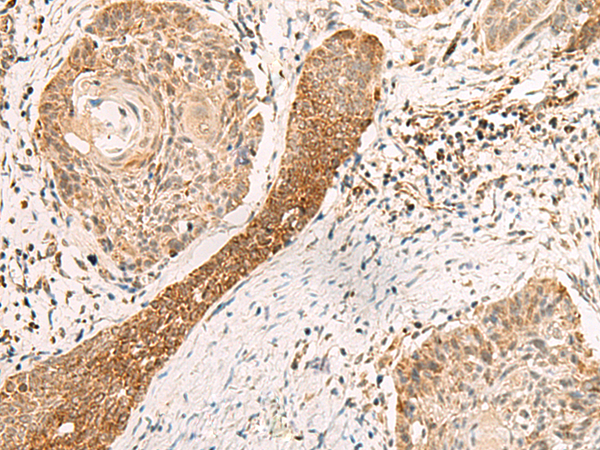
一抗

|
Background: |
Exonuclease required for double-strand breaks resection and efficient homologous recombination. Plays a key role in controlling the initial steps of chromosomal break repair, it is recruited to chromatin in a damage-dependent manner and functionally interacts with the MRN complex to accelerate resection through its 3'-5' exonuclease activity, which efficiently processes double-stranded DNA substrates containing nicks. |
|
Applications: |
ELISA, WB, IHC |
|
Name of antibody: |
EXD2 |
|
Immunogen: |
Fusion protein of human EXD2 |
|
Full name: |
exonuclease 3'-5' domain containing 2 |
|
Synonyms: |
EXDL2; C14orf114 |
|
SwissProt: |
Q9NVH0 |
|
ELISA Recommended dilution: |
5000-10000 |
|
IHC positive control: |
Human ovarian cancer |
|
IHC Recommend dilution: |
40-200 |
|
WB Predicted band size: |
70 kDa |
|
WB Positive control: |
Mouse testis tissue lysate |
|
WB Recommended dilution: |
200-1000 |



 購物車
購物車 幫助
幫助
 021-54845833/15800441009
021-54845833/15800441009